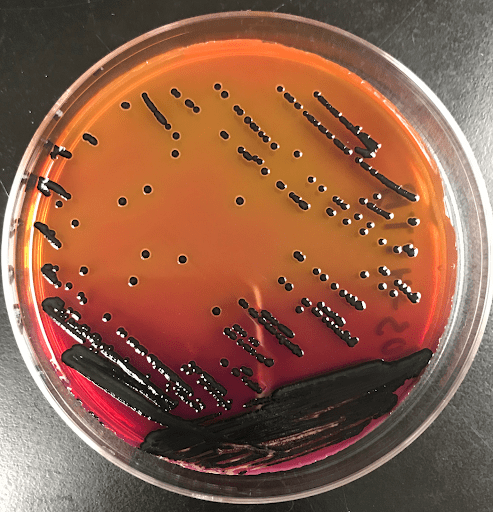

Improving Salmonella isolation
Typical Salmonella isolation typically takes 5-7 days and includes two overnight broth cultures: a non-selective pre-enrichment that allows resuscitation of injured Salmonella, followed by selective enrichment that limits the growth of background microflora. By combining these steps, we have developed protocols that reduce Salmonella isolation by a day.
Previous studies funded by USPE have focused on different sampling approaches such as drip line sampling as an alternative to carcass rinses or whole carcass enrichments as an alternative to carcass rinses.
Our group and others have observed variability in how Salmonella serovars respond to growth in different media. This can have large impacts on which serovars are isolated when a particular growth medium (e.g., selective enrichment broth) is used.
Relevant papers:
